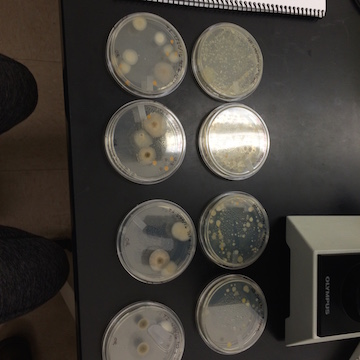

User:Matthew Kelly/Notebook/Biology 210 at AU
Zebrafish Lab March 23rd, 2016
Purpose:
The purpose of this lab was to identify the effects of caffeine on embryonic and early development of zebrafish..
Materials and Methods:
The experiment began by creating the solutions of water, 10 mg/L caffeine, and 40 mg/L caffeine. In order to create the 10 mg/L caffeine solution, the stock solution of 40 mg/L was diluted to 10 mg/L by using a ratio of 1 mL stock solution for every 3 mL of water added. To eliminate the need to do continuous dilutions throughout the two week experiment, a 100 mL of 10 mg/L solution was prepared in a flask and covered in parafilm to prevent evaporation. Twenty-four wells were filled with a solution: six control wells with water, six low exposure wells with 10 mg/L caffeine solution, and six high exposure wells with 40 mg/L caffeine solution. Zebrafish eggs were then pipetted into the wells, leaving two eggs per well. The wells were observed daily for a period of two weeks. When observing the fish, the fish were removed from their well and placed on a wet mount slide at 40x. Their heart rate, size, motility, survival and general characteristics were examined. The sixe was measured through an ocular micrometer and converted according to the appropriate conversion factor of 2.5. The heart rate was measured by counting the amount of seconds to reach 10 heartbeats via a timer. That figure was then reduced to heartbeat per second and multiplied by 60 to achieve heartbeats per minute. Motility was determined through comparison to the control population. Once the zebrafish hatched from their embryo, they were feed daily. Once had fluid removed from it, either via evaporation or through transferring zebrafish, the missing solution was replaced with the appropriate fresh solution. After one week, two living zebrafish were fixed and preserved in formaldehyde for later examination. At the conclusion of two weeks, any remaining zebrafish were also fixed. Results were no longer recorded once all zebrafish had died or been fixed.
Data and Observations:
Figure 1: Fixed control zebrafish
Figure 2: Fixed low exposure zebrafish
Figure 3: Fixed high exposure zebrafish
Control, low-exposure, and high exposure zebrafish were observed every day. Every embryo completed embryonic development by day 2. Development fully progressed over 14 days in the control population. Two from each population were fixed and preserved in formaldehyde. Size was similar amongst control and low exposure zebrafish, and smaller for high exposure zebrafish. Heart rate increased by large margin between control and low exposure populations, and was slightly higher for the high exposure population than the low-exposure. Mortality was fairly consistent amongst all three populations. By day 13, all exposed zebrafish had died. By day 14, all control zebrafish had died.
Conclusions and Future Directions:
Many conclusions can be drawn from the results found. First, caffeine does raise the heart rate significantly during early development. Second, caffeine stunts full development in terms of size, as was seen in the disparity of length as well as the observation of the objective width drawn throughout the experiment. Third, caffeine exposure leads to jittery, erratic, and quick movement both of the entire zebrafish as well as the eye of the zebrafish. Lastly, caffeine does not effect pigmentation. Unfortunately, results regarding the effect of caffeine on life span were inconclusive as most zebrafish of all populations died on a similar timeline. This does not prove that caffeine is safe, but rather suggests that an external factor most likely caused the death of the zebra fish. This factor may have come in potential contamination from the food source, where cross contamination was observed on a few occasions. It appears that caffeine, in reasonable amounts, did not harm embryonic development significantly, and appeared to have manageable effects during early development. These effects do make teen and childhood consumption of caffeine rather concerning in their potential long term effects. This supports the current practice of physicians in the United States of setting a limit of average recreational consumption of caffeine for pregnant women. However, results do suggest that further research should be conducted to determine if inconsistent caffeine exposure as well as extreme exposure during embryonic and early development would affect the heart rate and size. Results from such an experiment would assist in concluding if caffeine is a safe medical option in the treatment of headaches in pregnant women, children, and teens.
References:
References
“Caffeine Intake During Pregnancy”. July 2015. American Pregnancy Association. (1 Mar. 2016) <http://americanpregnancy.org/pregnancy-health/caffeine-during-pregnancy/>
“CID=2519”. PubChem Compound Database; 16 Sep. 2004. National Center for Biotechnology Information. (1 Mar. 2016) <https://pubchem.ncbi.nlm.nih.gov/compound/2519>
Denoeud, F., et al. 2014 The coffee genome provides insight into the convergent evolution of caffeine biosynthesis. 345: 1181-1184. (1 Mar. 2016)<http://science.sciencemag.org/content/345/6201/1181>
Somogyi, Lazlo P. “Caffeine Intake By The U.S. Population”. Dec. 2012. Food and Drug Administration. (1 Mar. 2016).<http://www.fda.gov/downloads/aboutfda/centersoffices/officeoffoods/cfsan/cfsanfoiaelectronicreadingroom/ucm333191.pdf>
Invertebrates Lab February 10th, 2016
Vertebrate Food Web March 2nd, 2016
Purpose:
The purpose of this lab was to identify the vertebrates present in transect two and to evaluate the ecological connections of the biotic and abiotic factors in transect 2.
Materials and Methods:
We researched the vertebrates and identified their impact as biotic factors in this micro biome.
Data and Observations:
Table 5.1: This table reveals the identity of each identified vertebrate from the phylum through the species.
Hawks nest atop trees and prey on organisms in this biome, such as brown rats, house sparrows, and northern cardinals. Northern cardinals and house sparrows nest in trees and prey on the earthworms, millipedes, and straw present in this transect. Brown rats consume the trash, scraps, and water while preying on crickets in this transect. Eastern fence lizards live off of the stream and prey on the earthworms of transect 2.
Conclusions and Future Directions:
With the information observed, we were able to create a food web showed below.
References:
Invertebrates Lab February 10th, 2016
16s sequencing February 24th, 2016
Purpose:
The purpose of this lab was to identify the gene sequences in bacteria from transect 2.
Materials and Methods:
We prepared a serial dilution that was spread on to agar plates. Each dilution was put onto one agar plate and one agar plate with tetracycline. We then prepared a Polymerase Chain Reaction to amplify the 16s rRNA gene. One week later we ran it through agarose gel and Ultraviolet light. We then used experimental data from a prior year in transect 2 to conclude the genus based on the genetic information using a database.
Data and Observations:
The Sequence found in transect 2 was:
CTCNTGTNACGGTNNNNNACTTCAGGTACCCCAGACTTCCATGGCTTGACGGGCG GTGTGTACAAGGCCCGGGAACGTATTCACCGCGCCATGGCTGATGCGCGATTACTAGCGATTCCAGCTTCATAGAGTCGA GTTGCAGACTCCAATCCGAACTGAGACCGGCTTTCGAGATTCGCATCACATCGCTGTGTAGCTGCCCTCTGTACCGGCCA TTGTATTACGTGTGTGGCCCAAGGCGTAAGGGCCGTGATGATTTGACGTCATCCCCACCTTCCTCTCTACTTGCGTAGGC AGTCTCACTAGAGTCCCCAACTTAATGATGGCAACTAGTGACAGGGGTTGCGCTCGTTGCAGGACTTAACCTAACACCTC ACGGCACGAGCTGACGACAACCATGCAGCACCTTGAAAAATGTCCGAAGAAAAGTCTATTTCTAAACCTGTCATTTCCCA TTTAAGCCTTGGTAAGGTTCCTCGCGTATCATCGAATTAAACCACATAATCCACCGCTTGTGCGGGCCCCCGTCAATTCC TTTGAGTTTCAGACTTGCGTCCGTACTCCCCAGGTGGCTAACTTATCACTTTCGCTTAGTCTCTGAATCCGAAAACCCAA AAACGAGTTAGCATCGTTTACGGCGTGGACTACCAGGGTATCTAATCCTGTTCGCTCCCCACGCTTTCGTCCATCAGCGT CAGTTGTTGCTTAGTAACCTGCCTTCGCAATTGGTGTTCTAAGTAATATCTATGCATTTCACCGCTACACTACTTATTCC AGCTACTTCAACAACACTCAAGACTTGCAGTATCAATGGCAGTTTCACAGTTAAGCTGTGAGATTTCACCACTGACTTAC AAATCCGCCTACGGACCCTTTAAACCCAATAAATCCCGGATAACGCTTGCACCCTCCGTATTACCGCGGCTGCTGGCACG GGAGTTAGCNNNGCTTANTCGTATAGTACCTTCAGCTAGATACACGTANNTNGGTTTATCCCTATACAAAGAAGTTTA
The sequence was identified as Chryseobacterium jejuense. This bacteria is aerobic, gram negative, yellow and bacillus.
Conclusions and Future Directions:
Our PCR did not work due to a failure in the primer. Thus, we had to base our sequence on bacteria from transect 2 last year. This gives us an idea of bacteria that could have been identified. The Chryseobacterium jejuense identified fits some of the characteristics of some of our bacteria that can be observed from the bacteria lab below.
References:
Invertebrates Lab February 10th, 2016
Purpose:
The purpose of this lab was to identify the invertebrates in transect 2.
Materials and Methods:
In this lab we took the remaining plant matter from last weeks lab and created a Burlese Funnel and allowed it to sit for one week. To prepare for the Burlese funnel, a 50 mL conical tube was filled with 25 mL of a 50:50 ethanol/water solution. A Burlese funnel was created by placing the plant matter in a funnel and attaching it to the conical tube via parafilm. After allowing the Burlese funnel to sit for one week, we removed the conical tube and evenly split the 25 mL in two petri dishes. We then examined the petri dishes under a dissecting microscope and identified organisms by using a dichotomous key for invertebrates.
Data and Observations:
Invertibrates
Figure 4.1: The Burlese Funnel
Table 4.1: Description of invertebrates found in the Burlese funnel sample
Figure 4.2: Invertebrate #1 in table 4.1
Figure 4.3: Invertebrate #2 in table 4.1
Figure 4.4: Invertebrate #3 in table 4.1
Figure 4.5: Invertebrate #4 in table 4.1
Figure 4.6: Invertebrate #5 in table 4.1
There were a total of 5 invertebrates identified in this experiment. One of the invertebrates was in the phylum Arachnida while the remaining were in the phylum "Anthropoda". Only one of the 5 invertebrates identified was clearly visible to the naked eye while the rest were only identifiable after using the directing microscope.
Conclusions and Future Directions:
The top half of the Berlese funnel yielded an Arachnid and Arthropod, both larger than the Arthropods found in the bottom half sample. The most common organisms in the Berelese funnel were arthropods. Based on the size of the arachnid versus the arthropod, we can conclude that the top sample had larger organisms which are able to float on top of the ethanol/water solution while the smaller organisms that cannot float on top have sunk t the bottom.
References:
Plants and Fungi Lab February 3rd, 2016
Purpose:
The purpose of this lab was to identify the plant and fungi life in transect 2.
Materials and Methods:
In this lab we went to our transect and removed plant matter from specific locations in the transect. We then took the plant matter back and observed the plant matter under a microscope to identify and study the plant organisms further. With the remaining plant matter, we created a Burlese Funnel and allowed it to sit for one week.
Data and Observations:
Plants
The plants were put under 40x magnification and are displayed below.
Table 3.1: This table details the 5 samples of plant life collected from transect 2
Figure 3.1: Ivy under 40x magnification
Figure 3.2: Tree leaf under 40x magnification
Figure 3.3: Fern leaf under 40x magnification
Figure 3.4: Fern spore under 40x magnification
Figure 3.5: Grass under 40x magnification
Figure 3.6: Shrub under 40x magnification
Conclusions and Future Directions:
Fungi sporangia is a sexual reproduction structure of fungi. It is important because it allows the fungi to create the spores necessary for reproduction. There was no fungus found in our plant matter, however, there is probably fungal growth somewhere in our transect given the sheer abundance of dead plant matter that needs to be decomposed. The plant matter we did find reveals that there is a diverse array of plant life within our transect. It is interesting how many different types of plants exist in transect two, however, I am even more intrigued in what we will find in our Burlese Funnel given the fact that transect 2 appears by the naked eye to be lacking an abundance of animal life.
References:
Bacteria Lab February 3rd, 2016
Purpose:
The purpose of this lab was to identify the microscopic bacteria that were living in transect 2.
Materials and Methods:
We prepared a serial dilution that was spread on to agar plates. Each dilution was put onto one agar plate and one agar plate with tetracycline. The bacteria grown was then run through a Gram Stain test and examined under a microscope at 40x to discover if each type of bacteria is gram negative or positive. We then prepared a Polymerase Chain Reaction to amplify the 16s rRNA gene. One week later we ran it through agarose gel and Ultraviolet light.
Data and Observations:
Bacteria:
Tetracycline is used in this experiment to kill bacteria and microbes so that tetracycline resistant bacteria may be discovered (Chopra, 2001). Tetracycline inhibits protein synthesis in the bacterial ribosomes in order to kill the bacterium. It is considered effective on both gram negative and positive bacteria. As of right now, there are 23 genera of gram positive bacteria and 39 of gram negative bacteria that have been determined to be tetracycline resistant.
The following image is of the Agar and Agar with tetracycline plates.The row closest to the microscope is the agar plates without tetracycline.
Image 2.5: Agar plates of the serial dilution and Agar plates with tetra cyclone of the same serial dilution.
The bacteria and fungi results from the agar and tetracycline plates are displayed below.
Table 2.1: 100-fold serial dilution results
Table 2.2: Gram Stain Table
Each bacteria sample was taken at 40x magnification.
Figure 2.1: Bacteria sample on wet mount from the agar plate of a dilution of 1 x 10^-5
Figure 2.2: Bacteria sample on wet mount from the agar plate of a dilution of 1 x 10^-7
Figure 2.3: Bacteria sample on wet mount from the tet+ plate of a dilution of 1 x 10^-7
Figure 2.4: Bacteria sample on wet mount from the tet+ plate of a dilution of 1 x 10^-9
Each bacteria sample was taken at 40x magnification.
Figure 2.5: Gram stained bacteria sample on wet mount from the agar plate of a dilution of 1 x 10^-5
Figure 2.6: Gram satined bacteria sample on wet mount from the agar plate of a dilution of 1 x 10^-7
Figure 2.7: Gram satined bacteria sample on wet mount from the tet+ plate of a dilution of 1 x 10^-7
Figure 2.8: Gram stained bacteria sample on wet mount from the tet+ plate of a dilution of 1 x 10^-9
The PCR amplification did not work properly and no results could be recorded.
Conclusions and Future Directions:
Before looking at the agar plates, we understood we would not discover archaea as archaea are found in extreme environments such as geysers. Given a lack of extreme conditions, archaea was not grown in transect 2's agar plates. There were clear differences in the plates bacterial growth. The agar plates with tetracycline seemed to have significantly less visible bacterial colonies. Of the colonies that were visible, the colonies in the agar plates with tetracycline were much larger on average. This is most likely because the tetracycline resistant bacteria has more nutrients to consume comparatively. Overall, the two clearly show that tetracycline is an antimicrobial agent that kills many bacteria and fungi. The PCR amplification did not work properly and thus was inconclusive.
References:
Chopra, Ian and Marilyn Roberts. "Tetracycline Antibiotics: Mode of Action, Applications, Molecular Biology, and Epidemiology of Bacterial Resistance". Jun. 2001. American Society for Microbiology. (5 Feb. 2016) <http://www.ncbi.nlm.nih.gov/pmc/articles/PMC99026/>
Bacteria, Algae and Protists Lab January 20th-27th, 2016
Purpose:
The purpose of this lab was to identify the microscopic protists and bacteria that were living in transect 2.
Materials and Methods:
We created a Hay Infusion and allowed it to sit for one week. We created wetmount slides from samples from 3 different sections of the Hay Infusion jar exactly one week after creating the Hay Infusion. We looked at the samples under 40x magnification. We used a dichotomous key to identify protists in the sample slides. We prepared a serial dilution that was spread on to agar plates. Each dilution was put onto one agar plate and one agar plate with tetracycline. The bacteria grown was then run through a Gram Stain test and examined under a microscope at 40x to discover if each type of bacteria is gram negative or positive. We then prepared a Polymerase Chain Reaction to amplify the 16s rRNA gene. One week later we ran it through agarose gel and Ultraviolet light.
Data and Observations:
Hay Infusion Description:
The Hay Infusion jar was comprised of plant matter, creek water, soil, and rocks. The jar had a strong odor of decomposing plants and mold. This was different from the prior weak, which was less pungent. The water was tinted brown last week, but as of this week the sediment has settled and the water is more clear. The water itself appear to have a plastic like film on the surface. The plant matter settled towards the bottom of the jar and appeared to compress over the two week period. The water was still and mold appeared to be growing along the sides of the top layer. In order to observe all of the possible protists, we took samples from the top of the water, the middle of the water, and the bottom of the water where the sediment had settled. Finding protists in the samples from the top and middle proved difficult. However, the sample from the bottom provided many protists.
Image2.1: Picture of the Hay Fusion from Transect 2
Protists Samples:
In the top and middle samples, we could not confidently identify any protists. However, we did identify 3 different protists in the bottom sample. The first identified was Blepharisma. It was not very motile organism with a brown tint. The sketch of the Blepharisma is pictured below.
Image2.2: Drawing of the observed Blepharisma
The next organism we identified was a Chilomonas. Unlike the Blepharisma, the Chilomonas was clearly motile. It measured to be 75 micrometers. The sketch of the Chilomonas is pictured below.
Image2.3: Drawing of the observed Chilomonas
The final organism we identified was a Paramecium. It was motile and measured at 2.5 micrometers.
Image2.4: Drawing of the observed Paramecium
Bacteria:
Tetracycline is used in this experiment to kill bacteria and microbes so that tetracycline resistant bacteria may be discovered (Chopra, 2001). Tetracycline inhibits protein synthesis in the bacterial ribosomes in order to kill the bacterium. It is considered effective on both gram negative and positive bacteria. As of right now, there are 23 genera of gram positive bacteria and 39 of gram negative bacteria that have been determined to be tetracycline resistant.
The following image is of the Agar and Agar with tetracycline plates.The row closest to the microscope is the agar plates without tetracycline.
Image 2.5: Agar plates of the serial dilution and Agar plates with tetra cyclone of the same serial dilution.
The bacteria and fungi results from the agar and tetracycline plates are displayed below.
Table 2.1: 100-fold serial dilution results
Table 2.2: Gram Stain Table
Each bacteria sample was taken at 40x magnification.
Figure 2.1: Bacteria sample on wet mount from the agar plate of a dilution of 1 x 10^-5
Figure 2.2: Bacteria sample on wet mount from the agar plate of a dilution of 1 x 10^-7
Figure 2.3: Bacteria sample on wet mount from the tet+ plate of a dilution of 1 x 10^-7
Figure 2.4: Bacteria sample on wet mount from the tet+ plate of a dilution of 1 x 10^-9
Each bacteria sample was taken at 40x magnification.
Figure 2.5: Gram stained bacteria sample on wet mount from the agar plate of a dilution of 1 x 10^-5
Figure 2.6: Gram satined bacteria sample on wet mount from the agar plate of a dilution of 1 x 10^-7
Figure 2.7: Gram satined bacteria sample on wet mount from the tet+ plate of a dilution of 1 x 10^-7
Figure 2.8: Gram stained bacteria sample on wet mount from the tet+ plate of a dilution of 1 x 10^-9
The PCR amplification did not work properly and no results could be recorded.
Conclusions and Future Directions:
The scent and appearance of the Hay Infusion has changed over the past two weeks. I hypothesize that this is due to the abundance of nutrients and environmental factors that allow fungi, molds, and bacteria to flourish in the Hay Culture. As plants are broken down and microbial life flourishes, the scent and appearance will continue to change. Before looking at the agar plates, we understood we would not discover archaea as archaea are found in extreme environments such as geysers. Given a lack of extreme conditions, archaea was not grown in transect 2's agar plates. There were clear differences in the plates bacterial growth. The agar plates with tetracycline seemed to have significantly less visible bacterial colonies. Of the colonies that were visible, the colonies in the agar plates with tetracycline were much larger on average. This is most likely because the tetracycline resistant bacteria has more nutrients to consume comparatively. Overall, the two clearly show that tetracycline is an antimicrobial agent that kills many bacteria and fungi. The PCR amplification did not work properly and thus was inconclusive.
References:
Chopra, Ian and Marilyn Roberts. "Tetracycline Antibiotics: Mode of Action, Applications, Molecular Biology, and Epidemiology of Bacterial Resistance". Jun. 2001. American Society for Microbiology. (5 Feb. 2016) <http://www.ncbi.nlm.nih.gov/pmc/articles/PMC99026/>
January 13th, 2016
Aerial Diagram of Transect 2
Image1.1
Abiotic factors:
-Water
-Rocks
-Soil
-Irrigation System
-Bricks
Biotic Factors:
-Trees
-Ferns
-Squirrels
-Grass
-Worms
Transect Description:
This transect begins with grass, rocks, ferns, and trees. These lead into a flowing creek that holds hundreds of rocks, ranging in size from massive rocks to pebbles. Typically, the larger rocks are towards the outside the creek, partially submersed in the water. the pebbles line the inside of the creek between the large rocks. On the opposing side of the creek, there is more grass, ferns, trees, and some moss on top of rocks. In the creek are rocks and broken branches. The weather appears to be heavily impacting life in this transect. Many plants seem to be dying and fallen leaves cover the majority of the transect. While it seems quiet now, I predict that it will be lively in the spring.
Transect 2 is a habitat with unique abiotic diversity for campus habitats. Within the transect there is a flowing creek, giving it a water source for both plants and animals. The rocks provide coverage for organisms looking to escape sunlight and to hide from potential predators. The rich soil with a consistent water source allows plant life to thrive in this transect. The abundance of plant life also allows this transect to provide a mix of different animal life, both predators and prey. On top of that, the water is also a home for a diverse group of organisms that are not visible to the naked eye.